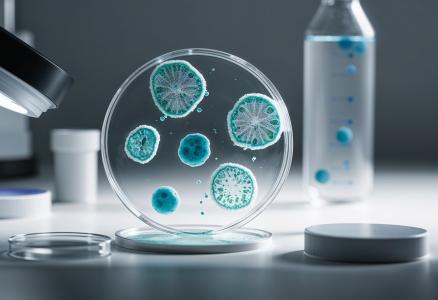
Cet outil permet d'étudier comment les bactéries partagent leurs gènes dans leur habitat naturel sans besoin de cultures en laboratoire (Visuel Adobe Stock 1045791706)

BACTÉRIOLOGIE : Un code-barre sans impact pour suivre le transfert de gènes
Un nouveau système universel de code-barres ARN qui permet de suivre le transfert de gènes chez les bactéries, promet des applications de grande envergure en médecine, en biotechnologie et en sciences de l'environnement. Cette méthode innovante de « code-barres » ARN, présentée dans la revue Nature Biotechnology ouvre la perspective d'étudier comment les bactéries partagent leurs gènes dans leur habitat naturel sans besoin de cultures en laboratoire. C’est une nouvelle ère de recherche microbienne et d'applications en biologie synthétique, plus durables.
Dans le monde microscopique des bactéries, le transfert de gènes est un mécanisme puissant
qui peut altérer la fonction cellulaire, favoriser l’antibiorésistance et même façonner des écosystèmes entiers. Lorsque les bactéries échangent des gènes, cela a un impact sur la santé humaine, la biotechnologie mais aussi la stabilité environnementale. Pouvoir, prochainement, cartographier les microbes impliqués dans le transfert de gènes offre un moyen direct d'enregistrer ces informations « en live » au sein même des environnements cellules.
Alors que les méthodes traditionnelles d'étude du transfert de gènes consistent à marquer des éléments génétiques mobiles avec des protéines fluorescentes ou des gènes de résistance aux antibiotiques, que ces approches nécessitent l'isolement et la culture de microbes en laboratoire, ce qui mobilise des technologies lourdes et limite leur utilisation dans des environnements complexes, ce nouvel outil de biologie synthétique, appelé « modification adressable par l'ARN » (RAM), contourne ces obstacles en utilisant un ARN synthétique pour coder l'ARN ribosomique (ARNr) à l'intérieur des cellules vivantes mêmes.
- En inscrivant l'information génétique directement dans l'ARNr 16S – une molécule universellement présente chez les bactéries –, les chercheurs peuvent, avec cette nouvelle technologie, identifier les microbes ayant acquis de l'ADN étranger, et cela sans perturber leur environnement naturel.
- Autre caractéristique plus durable, le séquençage ciblé de l'ARNr 16S étant la référence absolue pour l'identification des différentes espèces de bactéries, la nouvelle technologie s’appuie sur des protocoles et des logiciels d'analyse déjà éprouvés et faciles à utiliser.
- En clair, au lieu d'inscrire l'information de manière aléatoire dans l'ADN bactérien, ce qui est permanent et difficile à lire, l’outil RAM permet de la stocker dans une région de l'ARN hautement conservée, ce qui rend l'information peu coûteuse et facile à lire.
L’outil RAM peut être utilisé pour mesurer les différences de gammes d'hôtes entre les types de plasmides d'ADN. Avec des dizaines de milliers de plasmides d'ADN différents présents dans les microbes environnementaux naturels, la méthode RAM offre une méthode simple et économique pour commencer à comprendre la relation entre les plasmides et leurs hôtes.
En conclusion, ce nouvel outil qui permet de suivre le mouvement de multiples éléments génétiques au sein d'une communauté microbienne entière et naturelle, a des applications potentielles de grande envergure en médecine, en biotechnologie et en sciences de l'environnement.
L’une des applications les plus immédiate est la lutte contre la résistance aux antibiotiques, car le suivi de la propagation des gènes résistants dans les hôpitaux et les eaux usées pourrait aider à prédire et à prévenir les épidémies d'infections pharmacorésistantes. Mais la technologie a également le potentiel de concevoir des microbiomes capables de décomposer efficacement les polluants ou capables de remplir des tâches spécifiques,
comme la production de biocarburants ou de molécules pharmaceutiques et cela sur la base d’un transfert de gènes sûr et contrôlé.
Autres actualités sur le même thème
SANTÉ COGNITIVE : Elle préfère se mettre au vert
Actualité publiée il y a 1 année 7 moisTEMPÉRATURE, QUALITÉ de l’AIR : Quels effets sur la santé ?
Actualité publiée il y a 2 années 8 moisANTIBIORÉSISTANCE : Des gènes de résistance qui flottent dans les nuages
Actualité publiée il y a 2 années 11 moisMICROPLASTIQUES et PLASTISPHÈRE : Ils véhiculent la résistance aux antibiotiques
Actualité publiée il y a 3 mois 1 semaine




